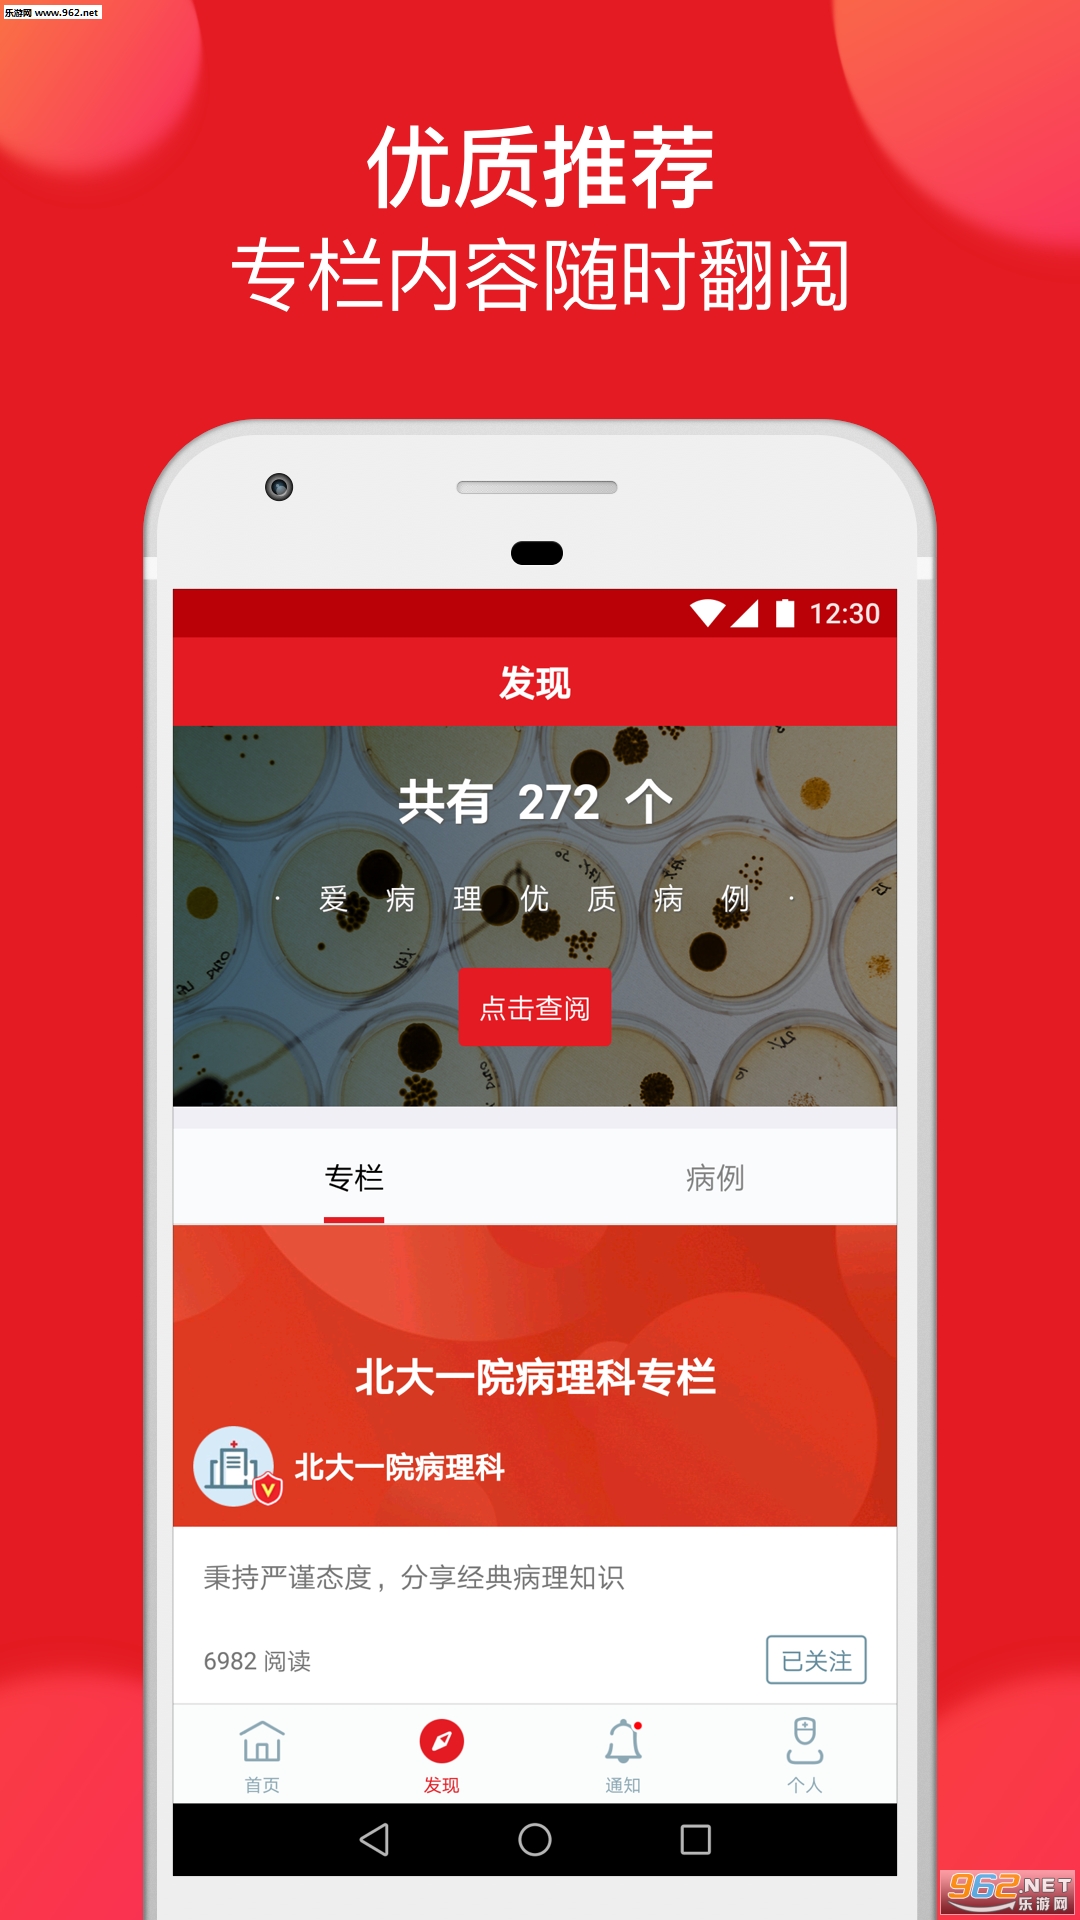

《爱病理app》是一款病理咨询分享软件,你可以使用这款软件来询问你的疑问,会有专家对你解答,还可以在平台上互相交流,共同学习。
软件介绍
“爱病理”是一个专为病理工作者打造,以诊断思路为交流核心的问答与分享平台
软件功能
1. 封闭社区:病理医生获取邀请码方可注册登录,没有广告
2. 便捷提问:流畅的图片编辑上传和病例信息添加功能
3. 快速回答:问题发布后快速有同行的诊断结果及思路的反馈
4. 优质分享:专家同行分享经典病例,详细讲解诊断思路
5. 个人病例库:永久收藏经典病例,打造属于自己的病例库



 粉碎僵尸城1.2.5
粉碎僵尸城1.2.5 街头赛车26.5.2
街头赛车26.5.2 奇妙的森林猫里奥1.1.4
奇妙的森林猫里奥1.1.4 高校模拟少女3.3
高校模拟少女3.3 银河控制3D战略59.6.29
银河控制3D战略59.6.29 BNF韩服v2.0.1
BNF韩服v2.0.1 指尖画家1.4.2
指尖画家1.4.2 模拟人生移动版国际服49.0.1.160658
模拟人生移动版国际服49.0.1.160658 爷爷和奶奶5起源v1.25
爷爷和奶奶5起源v1.25 世界末日生存(正版)1.12.2
世界末日生存(正版)1.12.2 维京崛起1.4.201
维京崛起1.4.201 命悬一日中文版6.4.0
命悬一日中文版6.4.0

头号公路1.0.0
头号公路1.0.0 会社少女5.2.0
会社少女5.2.0 疯狂夸父追神马1.0.27
疯狂夸父追神马1.0.27
 巅峰极速手机版0.9.1
巅峰极速手机版0.9.1
 扎心英雄1.0.1
扎心英雄1.0.1
 全民商战1.0.3
全民商战1.0.3
 这就是逆袭1.9.2
这就是逆袭1.9.2
 sans审判模拟器1.1
sans审判模拟器1.1
 幻兽爱合成单机版2.6.4
幻兽爱合成单机版2.6.4
 房间的秘密1.6.4.e8e4c646
房间的秘密1.6.4.e8e4c646
 易碎的虫子手机版1.2.8
易碎的虫子手机版1.2.8
 银河射手2.0.0
银河射手2.0.0
 果冻人快跑6.5.0
果冻人快跑6.5.0
 Austale0.4379
Austale0.4379
 粪作视觉小说(クソノベル)1.0.0
粪作视觉小说(クソノベル)1.0.0
 老爹炸鸡汉堡店中文版1.0.0
老爹炸鸡汉堡店中文版1.0.0
 盒子特工局100.0.0
盒子特工局100.0.0
 李四历险记2
李四历险记2 掌门霸图手游1.61
掌门霸图手游1.61 乌鸦森林之谜1.0
乌鸦森林之谜1.0 足球英雄22.03
足球英雄22.03 天使牡丹版1.10.34
天使牡丹版1.10.34 神兵mu(手游)0.0.4
神兵mu(手游)0.0.4 快递公司模拟器1.46
快递公司模拟器1.46 儿时的街机游戏
儿时的街机游戏
 拼图游戏大全
拼图游戏大全
 原神
原神
 生活实用APP
生活实用APP